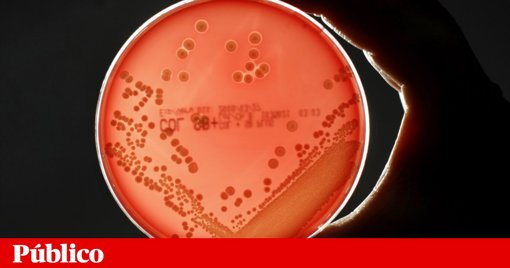
Dois projetos em Portugal conquistam prestigiadas Bolsas do Conselho Europeu de Investigação

Uma equipa liderada pela Universidade de Coimbra descobriu um mecanismo molecular chave na Doença de Batten, ligando a disfunção de uma proteína à morte celular através das vias de sinalização c-Abl e YAP1, o que abre portas a potenciais novas terapias para esta doença rara e fatal.